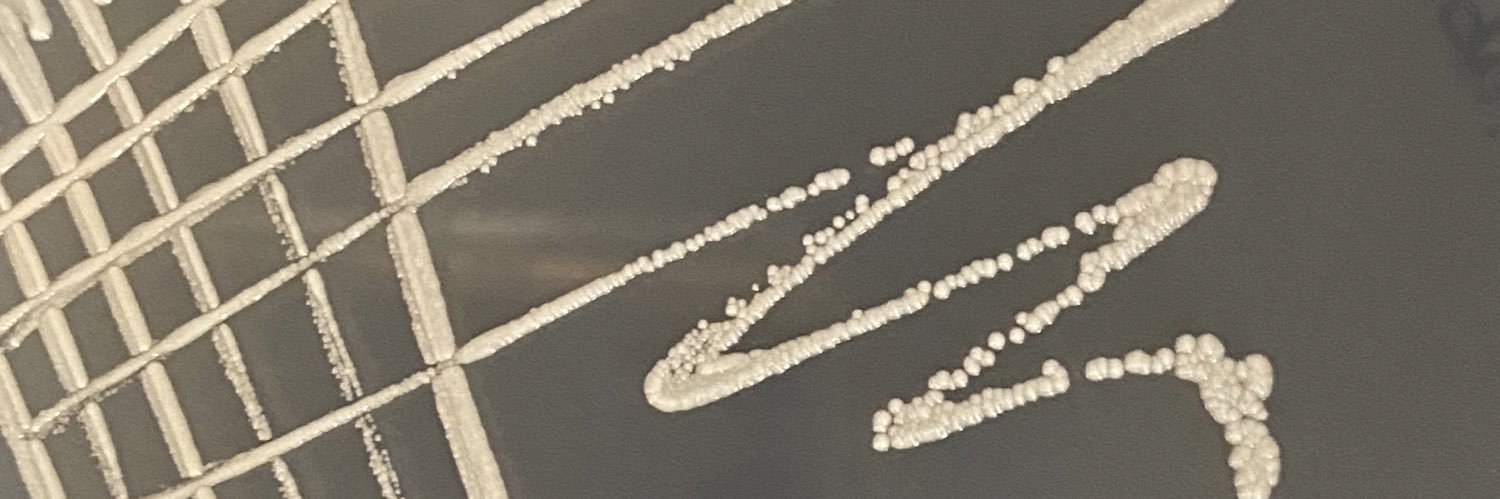
Claire Healy banner

Claire Healy
296 posts

Claire Healy
@healycl
Research Assistant Professor @suzcloo @tcdTBSI Formerly Postdoc Associate in @EhrtSchnapLab @WeillCornell #tuberculosis #NTM #respiratorypathogens #lungbiology










🚨 Interested in pathogen metabolic adaptations to the host? Come and join the project I'm coordinating @i3S_UPorto . (In sunny Portugal!) 🚨 Full announcement: lnkd.in/dDnv5vzc






















🌟 Calling all aspiring researchers! Dive into the world of host-pathogen interactions with a fully funded PhD opportunity at @McLoughlin_Lab @tcddublin. Visit wix.to/XmuowUz to apply today. #LoveIrishResearch @y_efis @yISI_ie @EFIS_Immunology



@dougveale is currently battling #PancreaticCancer in Boston for research trial of experimental #viraloncolytic drug. Please support #PancreaticCancer research for him & others @cancertrials_ie @svuh @UCD_Research gofund.me/5af93201